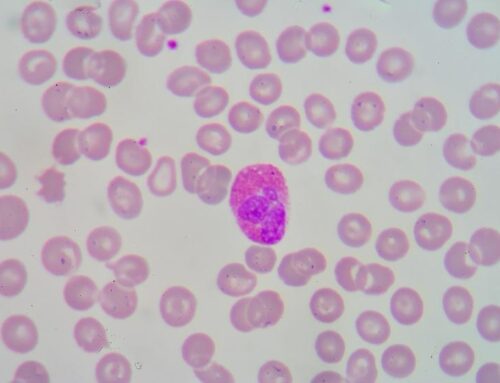
Eozinofilik özofajitte alerji testleri gerekir mi?

Genetik, çevresel faktörler ve immün sistem faktörleri ile ilgili olduğu düşünülmektedir. Besinlere bağlı ve daha az sıklıkta havada bulunan alerjenlerin yutulmasına bağlı; yemek borusunda enflamasyon dediğimiz iltihaplanmasının olması sonucu gelişmektedir. Genelde hastaların yarısında diğer alerjik hastalıklar da görülmektedir.